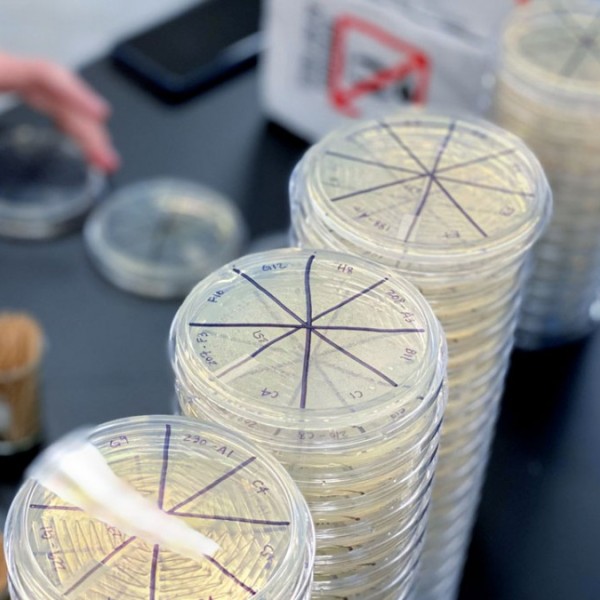
Clear round dishes sitting on a lab bench

Silver linings: Innovation, kits, tech animate a hybrid semester
Multimedia
News
She needed alcohol to preserve the soft-bodied insects she’d collected near her home in Missouri, for her entomology class at Cornell. But it wasn’t included in her box of supplies, because alcohol is too flammable to ship. Her local drug store...